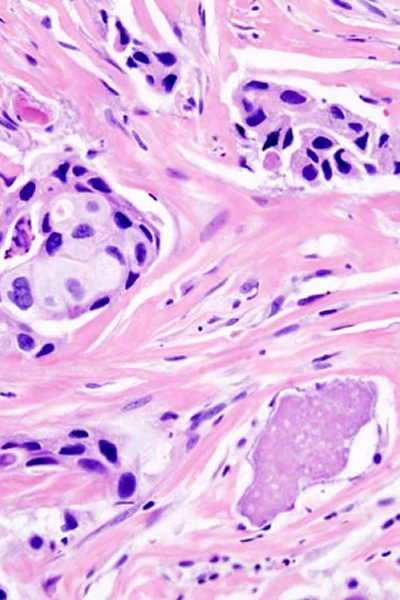

Integrating Medical Expertise into Healthcare Data Workflows


Collaborating with innovative leaders in Healthcare




































Structuring Medical Imaging and Clinical Data for Healthcare
Radiology
MRI, CT, PET and X-ray for diagnostic, research and treatment workflows.
- Organ-specific lesion and tumour segmentation
- 3D anatomical modelling (CT/MRI)
- Vessel, cardiac and MSK segmentation
- ROI identification for detection and triage AI
Clinical Trials
Voxel-precise, protocol-driven imaging review and segmentation to support clinical trials.
- Baseline and follow-up tumour segmentation
- Inter-rater reliability and peer-review workflows
- Multimodal PET/CT/MRI interpretation
- Image standardisation for multi-site studies

Surgery
High-fidelity 3D segmentation for surgical planning, simulation and intraoperative decision support.
- Organ and tissue modelling for digital twins
- Pre-operative anatomical mapping
- Vessel and nerve-pathway delineation
- Measurement sets for surgical planning

Dental
Annotation and image structuring for diagnostic dentistry and automated dental assessment tools.
- Tooth classification and numbering
- Detection of caries, fractures, implants and restorations
- Segmentation of jaws, roots and sinuses
- Landmarking for orthodontic planning and alignment

Pathology
Cell-level annotation and biomarker mapping for AI models in histopathology, oncology and precision medicine.
- Nuclear and cellular segmentation
- Biomarker and region-specific annotation
- Landmark-based morphology analysis
- High-resolution tile classification for whole-slide images

Clinical-Grade Imaging Annotation Across Organ Systems
Lung
Comprehensive Lesion Coverage
Segmentation across 18 lesion types, including nodules, emphysema, ground-glass opacities, irregular reticulation and septal thickening.
Clinically Defined Protocols
Annotation rules specify minimum lesion size, lesion boundaries and edge-case handling to maintain clinical relevance.
Accuracy for Challenging Cases
Workflows designed to optimise segmentation in diffuse or complex presentations, ensuring consistency across large imaging datasets.

Brain
Voxel-Precise Segmentation
Detailed annotation of infarcts, haemorrhages, tumours, cysts and other abnormalities across diverse CT and MRI sequences.
Structured Clinical Protocols
Protocols capture lesion type, volume and anatomical positioning, ensuring consistent interpretation across complex neuroimaging.
Expanded Regions of Interest
Support for additional ROIs such as aneurysms, fractures and atrophy to enable comprehensive neurological analysis.

Liver
Diagnostic and Interventional Support
Segmentation workflows tailored for diagnostic radiology and interventional procedures, including hepatocellular carcinoma and tumour ablation.
Anatomical Precision
Accurate delineation of liver interfaces such as parenchyma regions and portal vein territories, even in variable or complex cases.
Handling Clinical Variability
Processes adapted for challenges like fibrosis, fat content and atypical tumour boundaries to maintain consistent segmentation quality.

Vascular
Agnostic Vessel Segmentation
Segmentation across head & neck, thorax, abdomen, and lower limbs, covering major vessels and complex anatomical regions.
Critical Structure Analysis
Support for aorta-focused projects, including precise diameter measurements essential for aneurysm evaluation and clinical modelling.
Validated 3D Workflows
Voxel-level segmentation refined by radiologists, with optional pre-segmentation techniques for efficient review and adjustment.

Cardiac
Coronary CT Angiogram Analysis
Segmentation of cardiac structures to support stenosis detection and detailed assessment of coronary vessels.
3D Digital Twin Generation
Workflows designed to produce 3D models of the heart, enabling advanced planning and evaluation in cardiac imaging.
Precise Anatomical Delineation
Annotation of key areas including the endocardium, epicardium, ventricles and valves at both end-systole and end-diastole for complete functional analysis.

Muscoloskeletal
Comprehensive Fracture Identification
Annotation of subtle and complex fractures across chest and skeletal imaging, including hairline and low-contrast cases.
Landmark and Structural Analysis
Use of landmarks, polygons, and bounding boxes to assess bone alignment, cartilage structures and anatomical relationships.
Support for Diagnostic Challenges
Workflows adapted to overlapping structures, variable visibility and healing-stage differentiation to ensure consistent interpretation.

Others
Broad Modality Coverage
Annotation across additional organs and modalities, including spleen, kidneys, breast, ultrasound and PET imaging.
Integration of Clinical Reports
Use of DICOM metadata and radiology reports to refine region selection and ensure clinically relevant annotations.
Refinement by Domain Experts
Pre-segmented datasets reviewed and adjusted by radiologists and technologists to maintain accuracy across diverse imaging contexts.

Medical Expertise Built into a Compliant Data Frameworks
Intake & Compliance Setup
Domain Expertise
Quality Assurance
Feedback & Iteration
Deliverables
The Medical Experts Behind Compliant Data Workflows
Our domain expertise ensures accurate interpretation of medical imaging and consistency across large-scale clinical datasets.

Charles Arwin Latoja

DR Balbuena Viojan

















